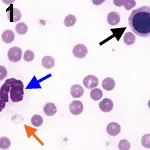
Featured Image

A 10-week-old, female domestic shorthair was presented with a history of listlessness several days in duration.
History. The cat had vomited 2 or 3 times the previous day. The client was not aware of toxins in the environment and had not given the cat any medications.
Physical Examination**.** The cat appeared cyanotic and stuporous. Dyspnea with panting respiration and moderate dehydration were observed. Its temperature was 39.6º C (104º F).
Laboratory Findings. The cat was anemic with normal MCV and increased MCHC as measured with a Cell-Dyn 3500 (Abbott Laboratories, www.abbott.com) (Table). The plasma was dark red when examined after centrifugation of a microhematocrit tube. Total plasma protein was within the reference interval as measured using a refractometer. Slight anisocytosis, slight polychromasia, and frequent erythrocytes with pale spots in the cytoplasm were visible in a stained blood film. Some erythrocyte "ghosts" with red inclusions in the cytoplasm were also noted (Figure 1). A platelet count was not done, but the number of platelets seemed to be normal on microscopic evaluation. The differential leukocyte count revealed marked leukocytosis, marked neutrophilia with 1+ toxicity and left shift, and slight monocytosis. Eosinophils and basophils were not seen, but nucleated erythrocytes were present.
Figure 1. Most erythrocytes have pale-staining cytoplasmic inclusions. An erythrocyte ghost containing a red-staining inclusion (orange arrow), a large metarubricyte (black arrow), and aneutrophil (blue arrow)are present. (Wright-Giemsa stain; original magnification, 1500¥)
Ask yourself ...
What specific term is used to describe the erythrocyte inclusions?
What type of disorder results in formation of these inclusions?
What might explain the cyanosis, and what test could you use to confirm your suspicion?
Diagnosis: Heinz body hemolytic anemia
The pale spots in the cytoplasm of most erythrocytes strongly suggest the presence of Heinz bodies, and the additional finding of erythrocyte ghosts (lysed erythrocytes) containing red inclusions strengthens this assumption.1 The presence of Heinz bodies was confirmed using a reticulocyte stain that colored the inclusions blue (Figure 2). Heinz bodies are inclusions that form within erythrocytes after oxidative denaturation and precipitation of the globin portion of hemoglobin. These inclusions bind to the inner surface of erythrocyte membranes and can result in premature erythrocyte phagocytosis.

Figure 2. Erythrocytes containing blue-staining Heinz bodies (reticulocyte stain; original magnification, 1500¥).
Intravascular hemolysis with hemoglobinemia and the presence of erythrocyte ghosts may also occur with severe membrane injury, as occurred in this cat. Some disorders that result in Heinz body formation also cause prominent methemoglobinemia. Methemoglobin (Fe+3) is unable to bind oxygen; consequently, animals with pronounced methemoglobinemia appear cyanotic and have evidence of respiratory difficulties, as reported in this cat. A spot test can be used to differentiate hypoxemia from methemoglobinemia. One drop of blood from the patient is placed on a piece of absorbent white paper, and a drop of normal control blood is placed next to it. If the methemoglobin content is 10% or greater, the patient's blood should have a noticeably brown coloration compared with the bright-red control blood (Figure 3).

Figure 3. Methemoglobin spot test. A drop of blood from a cat with 50% methemoglobin (left) was placed on absorbent white paper next to a drop of blood from a normal cat with less than 1% methemoglobin. (right). Reprinted from Atlas of Veterinary Hematology. Blood and Bone Marrow of Domestic Animals. Harvey JW. Philadelphia: WB Saunders Co, 2001, with permission from Elsevier.
Clinical Significance of Heinz Bodies. Healthy cats may have low numbers (< 5%) of erythrocytes containing small Heinz bodies. Some metabolic disorders (diabetes, hyperthyroidism, neoplasia, and inflammation) can generate oxidants in sufficient amounts to increase Heinz body formation and to reduce the life span of erythrocytes in cats, but anemia (when present) is generally mild.2 Certain therapeutic drugs, dietary constituents (such as onions, which can cause mild hemolytic anemia if consumed in sufficient quantities3), and chemicals (such as propylene glycol4) have the potential to induce oxidative injury to erythrocytes. Repeated propofol anesthesia has been reported to cause Heinz body formation in cats, but erythrocyte injury is not sufficiently severe to produce anemia.5 Clients may administer over-the-counter drugs, including acetaminophen and benzocaine, and veterinarians may administer prescription drugs, including methylene blue and phenazopyridine, that cause severe hemolytic anemia in cats.6
Did you answer ...
Heinz bodies
Presence of exogenous or endogenous oxidants
Methemoglobinemia can occur concomitant with Heinz body formation. Its presence can be confirmed with a methemoglobin spot test.
Case Report, Continued. Because of the severity of clinical and laboratory findings, drug-induced methemoglobinemia and Heinz body hemolytic anemia were suspected in this cat. Further investigation revealed that the day before presentation (unknown to the client) a friend who cared for the animal had given the cat approximately one quarter of an over-the-counter tablet containing 500 mg acetaminophen orally. Although this dose of drug seems small, the cat weighed only 0.9 kg. The hematocrit decreased to 12% 2 days after admission, and a whole blood transfusion was given, after which the cat made a full recovery.
The clinical findings in this case-including cyanosis, dyspnea, depression, and vomiting-have been reported in cats with acetaminophen toxicity. Although facial edema also occurs in some cats,7 it was not recognized in this case. Methemoglobinemia precedes Heinz body formation and hemolytic anemia in acetaminophen toxicity. The increased MCHC in this case was attributable to both hemolyzed plasma and the presence of Heinz bodies. As shown in this cat, the hematocrit should be monitored closely once Heinz body formation is identified, because the hematocrit usually does not reach its lowest point until several days after initial oxidant exposure. Marked leukocytosis and the presence of nucleated erythrocytes in blood have also been recognized in cats with acetaminophen toxicity.8
N-acetylcysteine is efficacious in treating acetaminophen toxicity if given within a few hours after drug administration.9 It was not given in this case because the diagnosis was not made for more than 24 hours. However, acetaminophen is slowly eliminated in cats, and it may be prudent to administer N-acetylcysteine if clinical signs are present, regardless of the time since drug administration.6 The recommended dosage is 140 mg/kg PO, followed by 70 mg/kg PO Q 6 H for 7 treatments.
HEMOLYTIC ANEMIA IN A CAT • John W. Harvey
References
1. Atlas of Veterinary Hematology. Blood and Bone Marrow of Domestic Animals. Harvey JW-Philadelphia: WB Saunders Co, 2001.2. Relation of endogenous Heinz bodies to disease and anemia in cats: 120 cases (1978-1987). Christopher MM. JAVMA 194:1089-1095, 1989.3. Heinz body formation in cats fed baby food containing onion powder. Robertson JE, Christopher MM, Rogers QR. JAVMA 212:1260-1266, 1998.4. Contribution of propylene glycol-induced Heinz body formation to anemia in cats. Christopher MM, Perman V, Eaton JW. JAVMA 194:1045-1056, 1989.5. Repetitive propofol administration in dogs and cats. Matthews NS, Brown RM, Barling KS, et al. JAAHA 40:255-260, 2004.6. Methemoglobinemia and Heinz-body hemolytic anemia. Harvey JW. In Bonagura JD (ed): Kirk's Current Veterinary Therapy XII. Small Animal Practice-Philadelphia: WB Saunders Co, 1995, pp 443-446.7. Acetaminophen toxicosis in small animals: Clinical signs, mode of action, and treatment. Cullison RF. Compend Contin Educ Pract Vet 6:315-321, 1984.
Acetaminophen toxicosis in the cat. Finco DR, Duncan JR, Schall WD, Prasse KW. JAVMA 166:469-472, 1975.9. Clinicopathologic evaluation of N-acetylcysteine therapy in acetaminophen toxicosis in the cat. Gaunt SD, Baker DC, Green RA. Am J Vet Res 42:1982-1984, 1981.